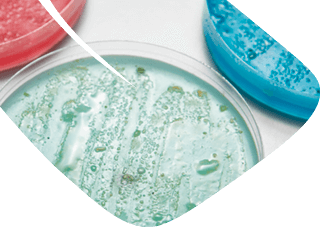

Tipos de ensayos
Nuestros laboratorios cuentan con una amplia experiencia en el análisis de contaminantes que pueden estar presentes en los entornos de laborales y comprometer la salud de los trabajadores.

Amianto
Nuestros laboratorios están especializados en la determinación de fibras de amianto y otras fibras en el aire, de acuerdo a la MTA/MA-051/A04.
La determinación de fibras de amianto en el ambiente de trabajo está regulada por el art. 5 del R.D. 396/2006, de 31 de marzo, por el que se establecen las disposiciones mínimas de seguridad y salud aplicables a los trabajos con riesgo de exposición al amianto.
Ambos centros acreditados por ENAC según norma UNE-EN ISO/IEC 17025:2017.
Adicionalmente disponemos de servicio de determinación de fibras de amianto según ISO 14966 por microscopía electrónica de barrido (SEM).

Sílice cristalina
Nuestros laboratorios están autorizados para el análisis de muestras de polvo y de sílice cristalina respirable de actividades incluidas en el marco del Reglamento General de Normas Básicas Mineras y su Instrucción Técnica Complementaria 2.0.02, aprobada en la Orden TED/723/2021.
Ambos centros están acreditados por ENAC, según la norma UNE-EN ISO/IEC 17025:2017.
Compuestos orgánicos volátiles
Ponemos a disposición de nuestros clientes una amplia variedad de tipos de ensayo para la determinación de diferentes familias de compuestos orgánicos volátiles (COV), así como de diferentes screenings (cetonas, glicoles, etc.).

Metales
Disponemos de diferentes packs para la determinación de metales en aire.

Otros ensayos
Efectuamos múltiples ensayos y screenings de compuestos habituales en algunos entornos laborales, tales como materia particulada, aldehídos, ácidos inorgánicos, aminas, hidrocarburos aromáticos policíclicos (HAP), etc.
